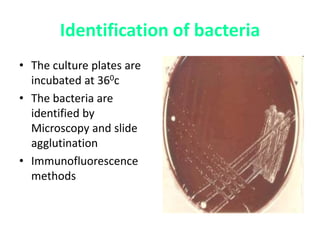
Identification of bacteria
• The culture plates are
incubated at 360c
• The bacteria are
identified by
Microscopy and slide
agglutination
• Immunofluorescence
methods

This document provides information on the Bordetella genus of bacteria, including B. pertussis, B. parapertussis, B. bronchiseptica, and B. avium. It describes their morphology, culture characteristics, virulence factors, mechanisms of infection, clinical manifestations of whooping cough caused by B. pertussis, epidemiology, laboratory diagnosis, treatment, and prophylaxis. Key points include that B. pertussis causes the most common form of whooping cough in humans and produces virulence factors like pertussis toxin and adenylate cyclase toxin that contribute to disease pathogenesis.